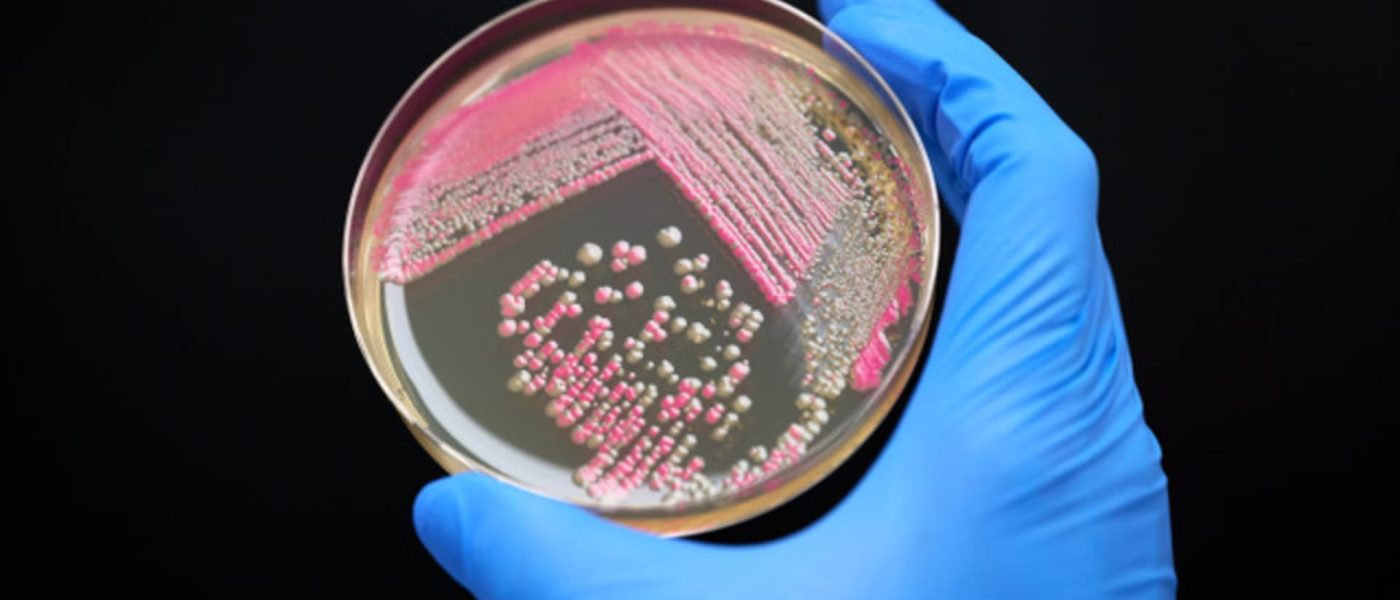

Biotech beauty company Debut brings new ingredients, products to skincare market
A Debut Biotech petri dish.
Courtesy: Debut Biotech
In a lab tucked away in southern California, scientists at Debut Biotech are testing molecules using advanced biotechnology to create new skincare formulations.
The San Diego-based company, founded nearly seven years ago, is pioneering new ingredients to specially target various aspects of skin health. One of the company’s latest innovations, an ingredient named EDL, will be used in a new skin-tightening product with Image Skincare scheduled to hit the shelves next year, CNBC has learned.
“The reason why we exist is we do believe that biology can make better things and it can deliver sustainable performance alternatives to what’s currently available for the world,” CEO Joshua Britton told CNBC.
The company focuses on identifying and copying molecules found in nature, refining and scaling those ingredients for their specific skin longevity benefits, and formulating them into products that satisfy consumer needs. Britton defined biotechnology as the use of advanced tech to “discover, validate and commercialize higher performing ingredients.”
But Debut’s “secret sauce,” he added, is the company’s vertically integrated company structure, which ensures it can perform its research and development and also see its products into the supply chain, all in-house.
“Like pharmaceutical companies, they own their manufacturing processes, they own the making of the product, they own the marketing around the product and they sell directly to doctors,” Britton said. “And so the synthetic biology industry had to learn that, overcome those issues, but now it’s taken off, and we’re seeing real change.”
Debut then works with its slate of clients, from beauty giant L’Oreal to smaller brands like Reome, to incorporate its ingredients into products and formulations.
Because of its vertical integration structure, Debut is able to speed up its process, Britton said, with iteration cycles taking just one to two weeks, allowing the company to ensure its discoveries make it directly into the hands of consumers.
“The investor base on the private and public side has always seen the promise of biotechnology but have always invested into companies who are horizontal and have unfortunately lost a lot of money,” Britton said. “But now the investors are starting to see things turn up in the supermarket, in the local market, in supply chains — we’re about to see this resurgence of biotechnology, and the resurgence this time will have a product focus, not a science focus.”
That structure is becoming increasingly important for beauty brands, according to Lindy Firstenberg, AlixPartners’ senior vice president of beauty and luxury. The consumer base is becoming more educated about the products they’re putting on their skin, with the rise of what Firstenberg calls the “consumer Ph.D.”
With the more knowledgeable customer, she said, comes a greater demand for hard science typically seen in the pharmaceutical sector.
“Because of that, you’ve seen this rise of vertical integration, and what it’s really doing is it’s delivering for the customer what they’re really asking for,” she told CNBC. “Because these consumers are asking for holistic programs, they’re thinking about infusions, injectables, ingestibles, topicals, tool therapy; they’re really looking for absolutely everything.”
In a world in which beauty and wellness have become deeply ingrained and intertwined with everyday routines, Firstenberg said she believes biotechnology in the industry is not just a fad and instead here to stay.
“I actually do think that you’ll end up having these beauty, health and wellness companies that are integrated, and they have different delivery methodologies and different delivery systems, because you’re going to have fewer beauty, health and wellness companies that can actually do it,” Firstenberg said. “The ones that can do it are really, really going to set themselves apart.”
Inside a lab at Debut Biotech with CEO Joshua Britton.
Courtesy: Debut Biotech
New innovations
Some of Debut’s ingredients are already on the market. Earlier this year, it partnered with Reome to introduce an ingredient named DHK, targeting skin barrier repair and derived from the Joshua Tree cactus in the desert.
Reome founder Joanna Ellner said using natural ingredients alone often produces inconsistent results based on varying harvests and can harm the environment, but biotech allows Reome to use those components in a more sustainable and consistent way.
“Based on the delivery system of biotech ingredients, we have the power to hit new levels of efficacy within skincare that have never been possible before,” Ellner told CNBC.
The company’s eye cream, featuring Debut’s DHK molecule, focuses on firming the skin around the eyes, and Ellner said it is 1.3 times more effective than standard ingredients like vitamin C.
“For me, the thrill is we are genuinely working with new ingredients, and we are generally at the very sharp end of innovation,” Ellner said. “We are not combining a bunch of pre-existing ingredients together and calling it a new word or some kind of compound — this is real.”
The new collaboration with Image Skincare features Debut’s EDL ingredient, which focuses on the viral topic of skin tightening. The company, which most recently developed a topical product to firm skin for GLP-1 patients experiencing rapid weight loss, aims to be at the forefront of innovation and new trends, according to CEO Sennen Pamich.
The new partnership with Debut aligned with just that, he added.
In initial clinical trials, Pamich said the company has seen the product’s ability to enhance skin longevity and vitality when combined with Image’s pre-existing formulations, including its technology that allows antioxidants to deeply penetrate the skin.
“There is a very high level of application of biotech in the pharmaceutical world, right? So why not in skincare and beauty?” Pamich said.
Future of biotech
Debut is still in the lab developing more biotech ingredients to target specific consumer concerns, like its new PNAR ingredient, which helps with hyperpigmentation.
While that process could take other companies close to two decades, the use of artificial intelligence and biotech to arrive at these ingredients allows Debut’s process to take just around a year, Britton added.
And that speed, efficiency and accuracy is why he believes biotech is the future of innovation, not just in beauty. While Debut chose the beauty sector specifically for its higher margins, Britton said he can see vertical integration and biotech being useful in a variety of other industries, like nutrition.
A lab at Debut Biotech.
Courtesy: Debut Biotech
That sentiment was echoed by Oliver Wright, Accenture’s global consumer industries lead, who emphasized that the technology’s ability to create targeted molecules while prioritizing sustainability will allow it to flourish.
According to research from Accenture, demand for bioengineered ingredients is expected to grow 15% to 20% annually through 2026, driven by Gen Z’s trust in science-backed solutions. The market for biotech skincare is expected to surpass $8 billion by 2031, according to Precision Business Insights.
“Biotech is about enhancing nature’s products – yes, it takes place in labs, but it is fundamentally about taking a human product that exists in nature and actually making sure that you refine that and create it for human benefit,” Wright told CNBC. “So people don’t need to be scared of it in the way that they might do otherwise.”
In other words, this new technology is moving the needle — and beauty giants like Sephora and Ulta will need to take notice and shape their messaging for consumers who may be overwhelmed by the plethora of options, Wright said.
Still, the next step is toward the “holy grail of cosmetics,” he said: personalized beauty. With the advent of generative AI and consumers’ growing knowledge of science and technology, Wright said he expects there to be a broadening of the definition of beauty to encapsulate wellness.
“I think the destination here is going to be the increasing ability for us to tailor this through diagnostics, through, therefore, product selection, but then increasingly towards actual personalization,” Wright said. “I think in effect, if we fast forward 10 years, that will be the normal in the industry.”
This article was originally published by a Cnbc.com. Read the Original article here. .